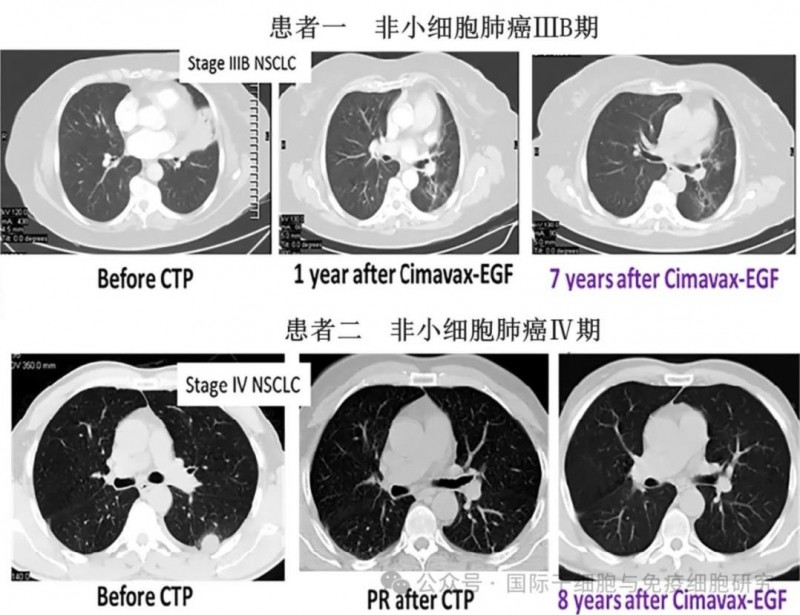
肺癌复发的原因找到了,六大肺癌预防复发的措施助您降低癌细胞"卷土重来"风险

肺癌肺癌KRAS G12C临床试验,加科思自主研发的KRASG12C抑制剂JAB-21822临床试验正在招募KRAS G12C突变的非小细胞肺癌患者
KRAS G12C临床试验,加科思自主研发的KRASG12C抑制剂JAB-21822临床试验正在招募KRAS G12C突变的非小细胞肺癌患者国研KRAS抑制剂-JAB-21822JAB-21822是一款由加科思自主研发的KRAS G12C抑制剂,目前已经在中国、美国及欧洲多国启动多项针对晚期实体瘤患者的临床试验项目,涵盖了JAB-21822单药以及与SHP2